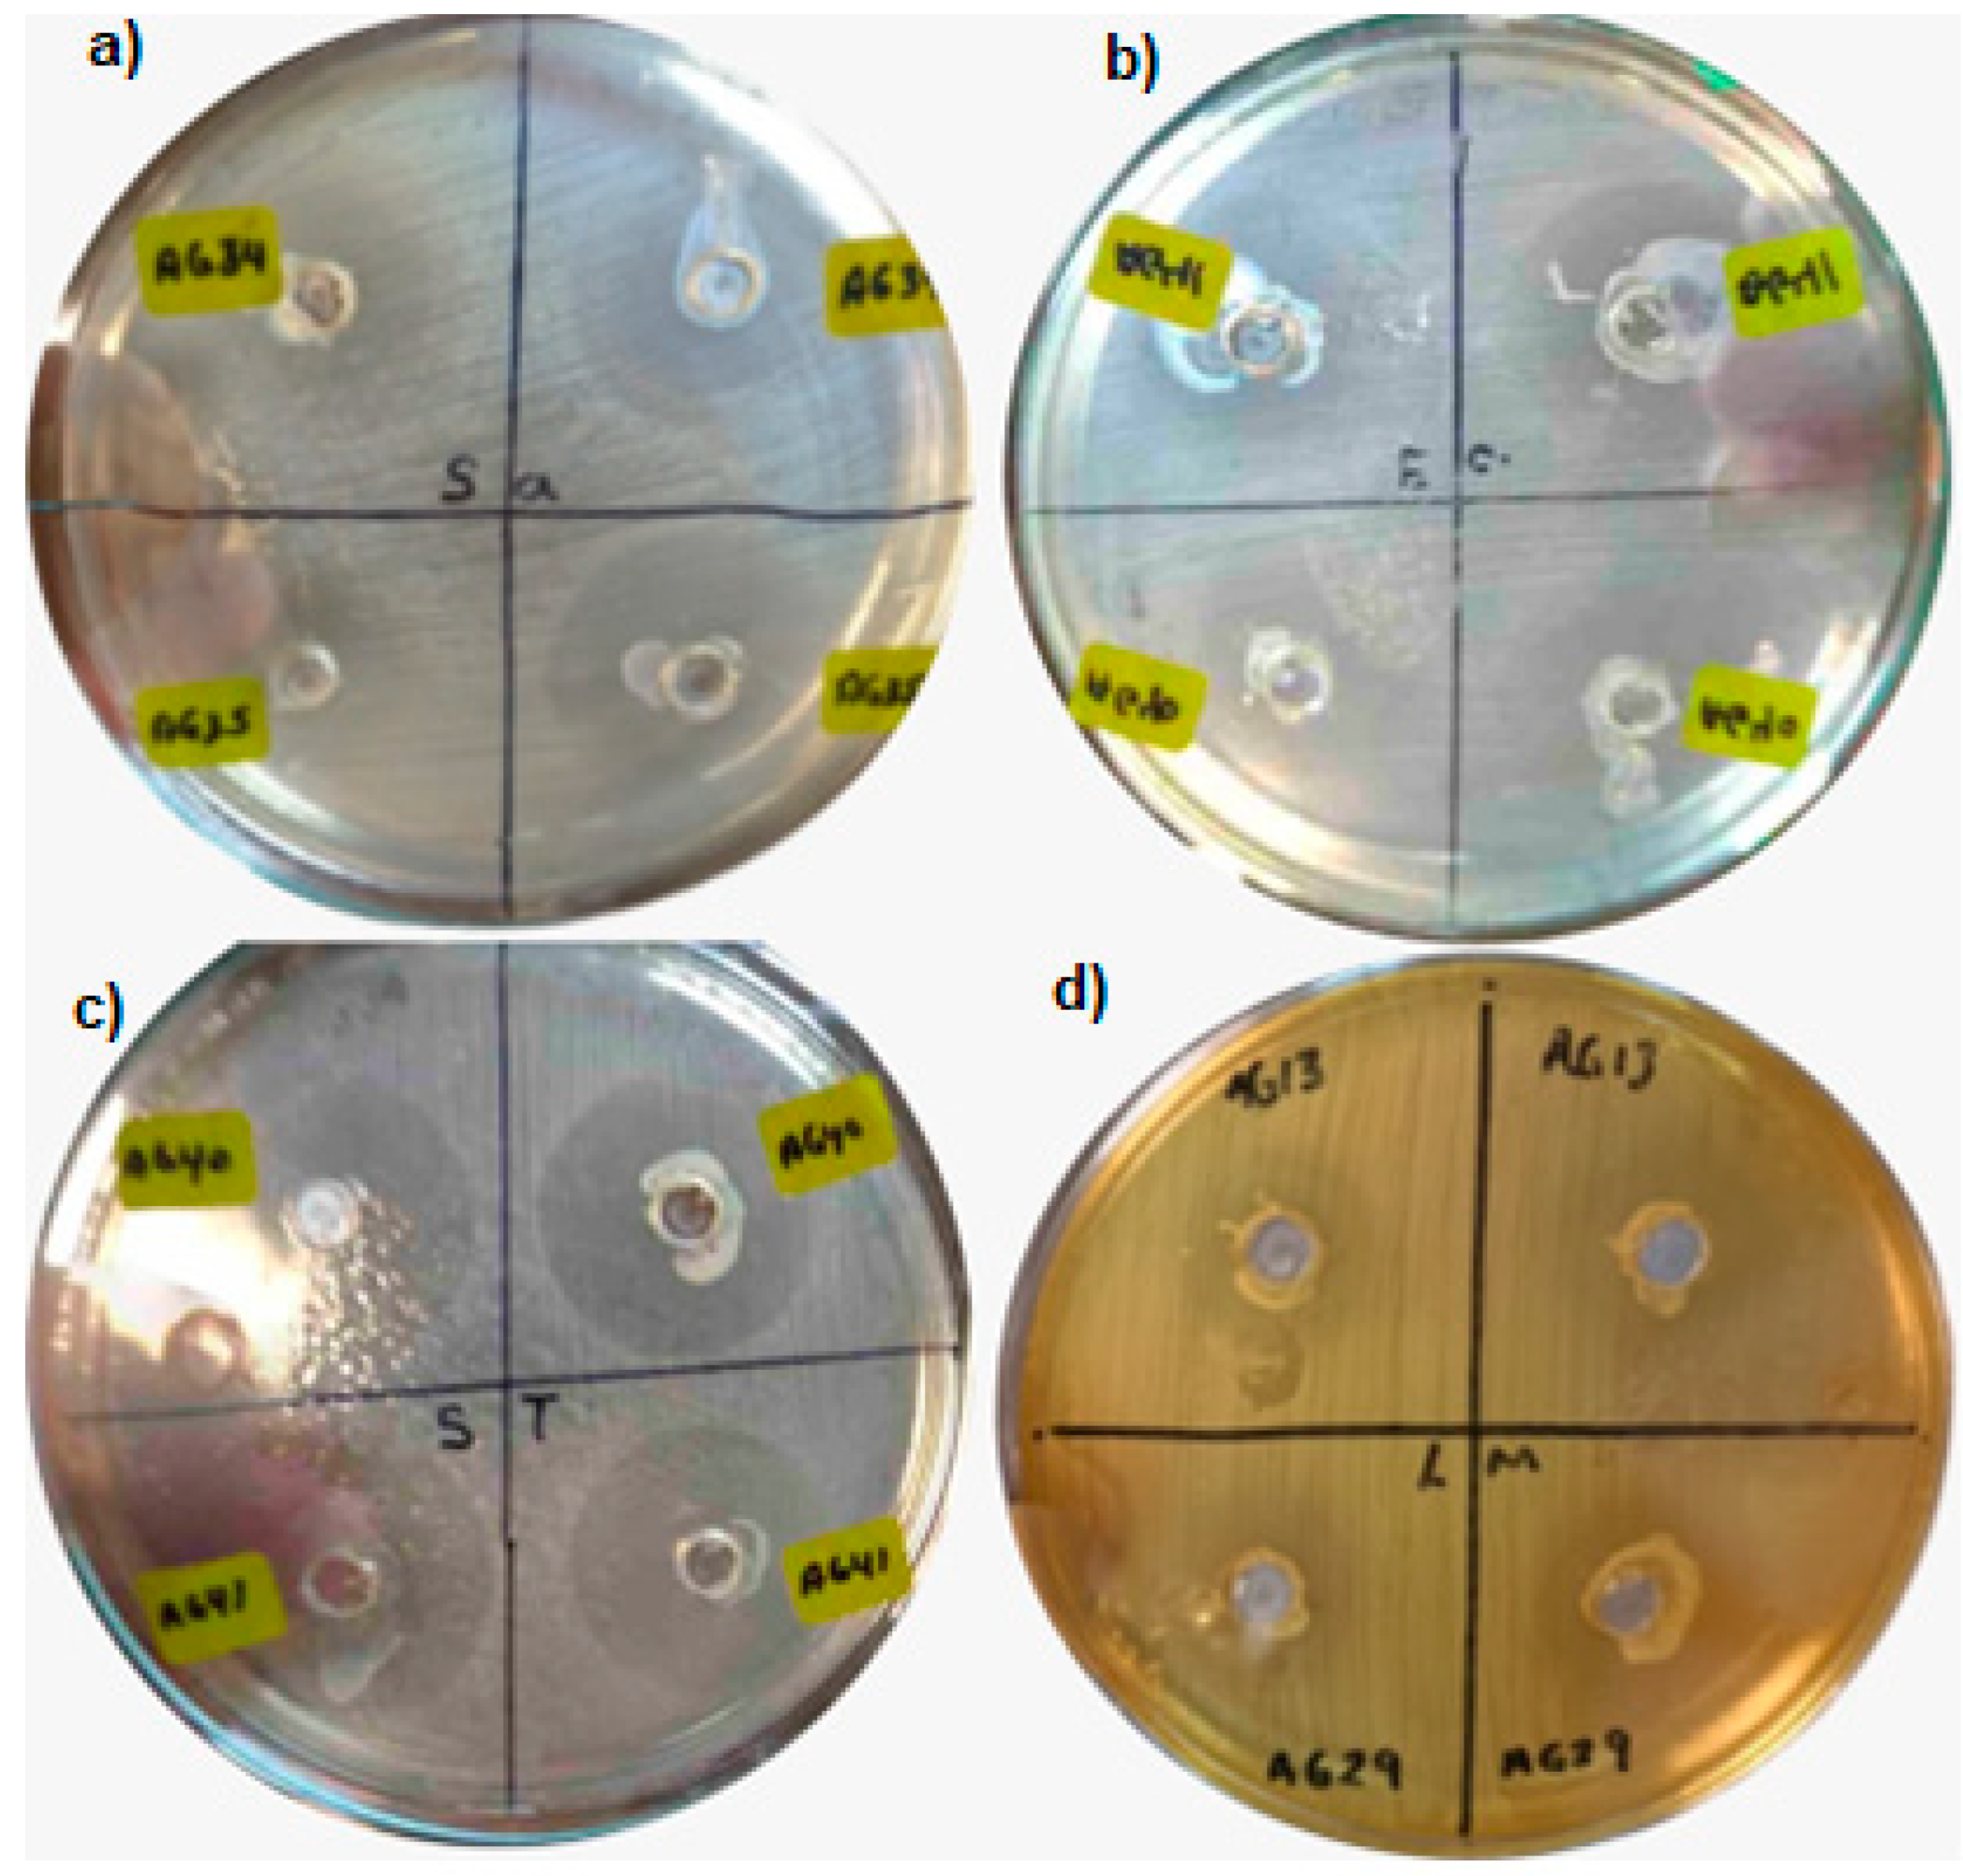
Fermentation 11 00474 g009

Probiotic Potential of Some Lactic Acid Bacteria Isolated from Blue Maize Atole Agrio from Veracruz, México
Abstract
1. Introduction
2. Materials and Methods
2.1. Plant Material
2.2. Preparation of Atole Agrio
2.3. pH Variation Measurement
2.4. Microbiological Analysis and Lactic Acid Bacteria (LAB) Isolation
2.5. Probiotic Potential and Characterization of LAB Isolates from Atole Agrio
2.5.1. Tolerance to Different pH Values
2.5.2. Resistance to Bile Salts
2.5.3. Halotolerance of the Isolates
2.5.4. Hydrophobicity of the Cell Wall
2.5.5. Autoaggregation Assay
2.5.6. Coaggregation Test
2.5.7. Antimicrobial Activity
2.5.8. Amylolytic Activity
2.5.9. Safety Testing
Hemolytic Activity
Antibiotic Susceptibility
2.6. Identification of Isolates Using the System VITEK® MS
2.7. Statistical Analysis
3. Results and Discussion
3.1. pH Variation and Microbial Counts During Atole Agrio Preparation
3.2. Isolation of Lactic Acid Bacteria
3.3. Probiotic Potential Determination of the LAB Isolates
3.3.1. Tolerance to Different pH Values
| Isolate Code | Morphology | pH 2 | pH 2.5 | pH 3 |
|---|---|---|---|---|
| AG13 | Coccus | 100 ± 0.0 | 100 ± 0.0 | 100 ± 0.0 |
| AG19 | Long bacillus | 81.4 ± 1.7 | 100 ± 0.0 | 100 ± 0.0 |
| AG22 | Short bacillus | 92.5 ± 1.8 | 100 ± 0.0 | 100 ± 0.0 |
| AG23 | Short bacillus | 100 ± 0.0 | 100 ± 0.0 | 100 ± 0.0 |
| AG24 | Short bacillus | 90 ± 1.5 | 100 ± 0.0 | 100 ± 0.0 |
| AG25 | Short bacillus | 95 ± 0.5 | 100 ± 0.0 | 100 ± 0.0 |
| AG 26 | Short bacillus | 100 ± 0.0 | 100 ± 0.0 | 100 ± 0.0 |
| AG 27 | Short bacillus | 81 ± 1.7 | 95 ± 1.5 | 100 ± 0.0 |
| AG 29 | Coccus | 90 ± 1.5 | 100 ± 0.0 | 100 ± 0.0 |
| AG 34 | Coccus | 95 ± 1.5 | 100 ± 0.0 | 100 ± 0.0 |
| AG 35 | Coccus | 100 ± 0.0 | 100 ± 0.0 | 100 ± 0.0 |
| AG 39 | Coccus | 95 ± 1.8 | 100 ± 0.0 | 100 ± 0.0 |
| AG 40 | Coccus | 95 ± 1.7 | 95 ± 1.5 | 100 ± 0.0 |
| AG 41 | Coccus | 90 ± 1.5 | 100 ± 0.0 | 100 ± 0.0 |
| AG 42 | Short bacillus | 94 ± 1.5 | 100 ± 0.0 | 100 ± 0.0 |
| AG 43 | Coccus | 100 ± 0.0 | 100 ± 0.0 | 100 ± 0.0 |
3.3.2. Bile Salt Tolerance
3.3.3. Identification of Isolates Using the Vitek MS Plus System
3.3.4. Halotolerance of LAB Isolated from the Fermentative Process of Atole Agrio
3.3.5. Hydrophobicity of the Cell Wall
3.3.6. Autoaggregation

3.3.7. Coaggregation
3.3.8. Antibacterial and Amylolytic Activities
| Isolate Code | Antibacterial Activity (Halo Diameter in mm Measured after 24 h of Incubation at 37 °C) | Amylolytic Activity | |||
|---|---|---|---|---|---|
| Sa * | St * | Ec * | Lm * | ||
| AG13 | 15.5 ± 0.38 | 8 ± 0.18 | 11.5 ± 0.35 | 12.5 ± 0.31 | + |
| AG29 | 12 ± 0.23 | 7.5 ± 0.14 | 11 ± 0.32 | 11 ± 0.36 | + |
| AG34 | 14 ± 0.39 | 10 ± 0.24 | 12.5 ± 0.45 | 14.5 ± 0.42 | + |
| AG35 | 24.5 ± 0.65 | 9.5 ± 0.21 | 15 ± 0.41 | 13 ± 0.38 | + |
| AG40 | 10.5 ± 0.29 | 22.5 ± 0.55 | 15.5 ± 0.40 | 14 ± 0.24 | + |
| AG41 | 12.5 ± 0.33 | 20 ± 0.36 | 23.5 ± 0.65 | 11 ± 0.32 | + |
| AG43 | 17.5 ± 0.33 | 11.5 ± 0.38 | 16.5 ± 0.40 | 12.6 ± 0.39 | + |
3.3.9. Safety Testing
Hemolytic Activity
Antibiotic Susceptibility
3.3.10. Pediococcus pentosaceus
4. Conclusions
Supplementary Materials
Author Contributions
Funding
Institutional Review Board Statement
Informed Consent Statement
Data Availability Statement
Acknowledgments
Conflicts of Interest
Abbreviation
| LAB | Lactic acid bacteria |
References
- Mora-Rochín, S.; Gaxiola-Cuevas, N.; Gutiérrez-Uribe, J.A.; Milán-Carrillo, J.; Milán-Noris, E.; Reyes-Moreno, C.; Serna-Saldívar, S.; Cuevas-Rodríguez, E. Effect of traditional nixtamalization on anthocyanin content and profile in Mexican blue maize (Zea mays L.) landraces. LWT-Food Sci. Technol. 2016, 68, 563–569. [Google Scholar] [CrossRef]
- Camelo-Méndez, G.A.; Agama-Acevedo, E.; Tovar, J.; Bello-Pérez, L.A. Functional study of raw and cooked blue maize flour: Starch digestibility, total phenolic content and antioxidant activity. J. Cereal Sci. 2017, 76, 179–185. [Google Scholar] [CrossRef]
- Dorantes-Campuzano, M.; Cabrera-Ramírez, A.; Rodríguez-García, M.; Palacios-Rojas, N.; Preciado-Ortiz, R.; Luzardo-Ocampo, I.; Gaytán, M. Effect of maize processing on amylose-lipid complex in pozole, a traditional Mexican dish. Appl. Food Res. 2022, 2, 100078. [Google Scholar] [CrossRef]
- Castillo-Morales, M.; Wacher-Rodarte, M.C.; Hernández-Sánchez, H. Preliminary studies on chorote—A traditional Mexican fermented product. World J. Microbiol. Biotechnol. 2005, 21, 293–296. [Google Scholar] [CrossRef]
- Sánchez-Dirzo, M.G.; López-Ferrer, C.E.; Flores-Valadez, M.; Jofre-Garfias, A.L.; Aguirre-Rodríguez, J.A.; Morales-Cruz, E.J.; Reyes-Chilpa, R. Estudio preliminar del Axokot, bebida tradicional fermentada, bajo una perspectiva transdisciplinaria. Inv. Univ. Multidiscip. 2010, 9, 113–124. [Google Scholar]
- Rubio-Castillo, A.E.; Santiago-López, L.; Vallejo-Cordoba, B.; Hernández-Mendoza, A.; Sáyago-Ayerdi, S.; González-Córdova, A.F. Traditional non-distilled fermented beverages from Mexico based on maize: An approach to Tejuino beverage. Int. J. Gastron. Food Sci. 2021, 23, 100283. [Google Scholar] [CrossRef]
- Pérez-Armendáriz, B.; Cardoso-Ugarte, G.A. Traditional fermented beverages in Mexico: Biotechnological, nutritional, and functional approaches. Food Res. Int. 2020, 136, 109307. [Google Scholar] [CrossRef]
- Ramos, P.; Tuaño, A.; Juanico, C. Microbial quality, safety, sensory acceptability, and proximate composition of a fermented nixtamalized maize (Zea mays L.) beverage. J. Cereal Sci. 2022, 107, 103521. [Google Scholar] [CrossRef]
- Väkeväinen, K.; Valderrama, A.; Espinosa, J.; Ceturión, D.; Rizo, J.; Reyes-Duarte, D.; Díaz-Ruiz, G.; von Wright, A.; Elizaquível, P.; Esquivel, K.; et al. Characterization of lactic acid bacteria recovered from atole agrio, a traditional Mexican fermented beverage. LWT-Food Sci. Technol. 2018, 88, 109–118. [Google Scholar] [CrossRef]
- Pérez-Cataluña, A.; Elizaquível, P.; Carrasco, P.; Espinosa, J.; Reyes, D.; Wacher, C.; Aznar, R. Diversity and dynamics of lactic acid bacteria in Atole agrio, a traditional maize-based fermented beverage from South-Eastern Mexico, analysed by high throughput sequencing and culturing. Antonie Van Leeuwenhoek 2018, 111, 385–399. [Google Scholar] [CrossRef]
- Manini, F.; Casiraghi, M.C.; Poutanen, K.; Brasca, M.; Erba, D.; Plumed-Ferrer, C. Characterization of lactic acid bacteria isolated from wheat bran sourdough. LWT—Food Sci. Technol. 2016, 66, 275–283. [Google Scholar] [CrossRef]
- Adugna, M.; Andualem, B. Isolation, characterization and safety assessment of probiotic lactic acid bacteria from metata ayib (Traditional spiced cottage cheese). Food Humanit. 2023, 1, 85–91. [Google Scholar] [CrossRef]
- Atol Agrio. Available online: https://www.arecetas.com/articulos/atol-agrio/ (accessed on 21 July 2025).
- González-Quijano, G.K.; Dorantes-Alvarez, L.; Hernández-Sánchez, H.; Jaramillo-Flores, M.E.; Perea-Flores, M.J.; Vera-Ponce de León, A.; Hernández-Rodríguez, C. Halotolerance and Survival Kinetics of Lactic Acid Bacteria Isolated from Jalapeño Pepper (Capsicum annuum L.) Fermentation. J. Food Sci. 2014, 79, M1545–M1553. [Google Scholar] [CrossRef]
- Oviedo-Leon, J.F.; Cornejo-Mazon, M.; Ortiz-Hernandez, R.; Torres-Ramírez, N.; Hernández Sánchez, H.; Castro-Rodríguez, D.C. Exploration adhesion properties of Liquorilactobacillus and Lentilactobacillus isolated from two different sources of tepache kefir grains. PLoS ONE 2024, 19, e0297900. [Google Scholar] [CrossRef]
- Krausova, G.; Hyrslova, I.; Hynstova, I. In vitro evaluation of adhesion capacity, hydrophobicity, and auto-aggregation of newly isolated potential probiotic strains. Fermentation 2019, 5, 100. [Google Scholar] [CrossRef]
- Wójcik, R.; Małaczewska, J.; Tobolski, D.; Miciński, J.; Kaczorek-Łukowska, E.; Zwierzchowski, G. The Effect of Orally Administered Multi-Strain Probiotic Formulation (Lactobacillus, Bifidobacterium) on the Phagocytic Activity and Oxidative Metabolism of Peripheral Blood Granulocytes and Monocytes in Lambs. Int. J. Mol. Sci. 2024, 25, 5068. [Google Scholar] [CrossRef]
- Collado, M.C.; Meriluoto, J.; Salminen, S. Adhesion and aggregation properties of probiotic and pathogen strains. Eur. Food Res. Technol. 2008, 226, 1065–1073. [Google Scholar] [CrossRef]
- Cox, C.R.; Voorhees, K.J. Bacterial identification by mass spectrometry. In Detection of Chemical, Radiological and Nuclear Agents for the Prevention of Terrorism; NATO Science for Peace and Security Series A: Chemistry and Biology; Banoub, J., Ed.; Springer Science+Business Media: Dordrecht, The Netherlands, 2014; pp. 115–131. [Google Scholar]
- Fonseca, L.M.; Halal, S.L.M.E.; Dias, A.R.G.; Zavareze, E.R. Physical modification of starch by heat-moisture treatment and annealing and their applications: A review. Carbohydr. Polym. 2021, 274, 118665. [Google Scholar] [CrossRef] [PubMed]
- Khoo, H.E.; Azlan, A.; Tang, S.T.; Lim, S.M. Anthocyanidins and anthocyanins: Colored pigments as food, pharmaceutical ingredients, and potential health benefits. Food Nutr. Res. 2017, 61, 1361779. [Google Scholar] [CrossRef] [PubMed]
- Li, J.; Zhu, B.; Yu, H.; Yuan, M.; Chen, H.; Qin, Y. Application of pH-indicating film containing blue corn anthocyanins on corn-starch/polyvinyl alcohol as substrate for preservation of tilapia. J. Food Meas. Charact. 2022, 16, 4416–4424. [Google Scholar] [CrossRef]
- Otunba, A.A.; Osuntoki, A.A.; Olukoya, D.K.; Babaola, B.A. Genomic, biochemical and microbial evaluation of probiotic potentials of bacterial isolates from fermented sorghum products. Heliyon 2021, 7, e08536. [Google Scholar] [CrossRef]
- Cizeikene, D.; Juodeikiene, G.; Paskevicius, A.; Bartkiene, E. Antimicrobial activity of lactic acid bacteria against pathogenic and spoilage microorganism isolated from food and their control in wheat bread. Food Control 2013, 31, 539–545. [Google Scholar] [CrossRef]
- Wang, C.; Cui, Y.; Qu, X. Mechanisms and improvement of acid resistance in lactic acid bacteria. Arch. Microbiol. 2018, 200, 195–201. [Google Scholar] [CrossRef]
- Icer, M.A.; Özbay, S.; Ağagündüz, D.; Kelle, B.; Bartkiene, E.; Rocha, J.M.F.; Ozogul, F. The Impacts of Acidophilic Lactic Acid Bacteria on Food and Human Health: A Review of the Current Knowledge. Foods 2023, 12, 2965. [Google Scholar] [CrossRef] [PubMed]
- Chaudhary, A.; Singh Saharan, B. Probiotic properties of Lactobacillus plantarum. J. Pure Appl. Microbiol. 2019, 13, 933–948. [Google Scholar] [CrossRef]
- Heunis, T.; Deane, S.; Smit, S.; Dicks, L.M.T. Proteomic profiling of the acid stress response in Lactobacillus plantarum 423. J. Proteom. Res. 2014, 13, 4028–4039. [Google Scholar] [CrossRef]
- Sánchez, B.; Bressollier, P.; Urdaci, M.C. Exported proteins in probiotic bacteria: Adhesion to intestinal surfaces, host immunomodulation and molecular cross-talking with the host. FEMS Immunol. Med. Microbiol. 2008, 54, 1–17. [Google Scholar] [CrossRef] [PubMed]
- Szutowska, J.; Gwiazdowska, D. Probiotic potential of lactic acid bacteria obtained from fermented curly kale juice. Arch. Microbiol. 2021, 203, 975–988. [Google Scholar] [CrossRef] [PubMed]
- Begley, M.; Hill, C.; Gahan, C.G.M. Bile salt hydrolase activity in probiotics. Appl. Environm. Microbiol. 2006, 72, 1729–1738. [Google Scholar] [CrossRef] [PubMed]
- Gil-Rodríguez, A.M.; Beresford, T. Bile salt hydrolase and lipase inhibitory activity in reconstituted skim milk fermented with lactic acid bacteria. J. Funct. Foods 2021, 77, 104342. [Google Scholar] [CrossRef]
- Španová, A.; Dráb, V.; Turková, K.; Špano, M.; Burdychová, R.; Šedo, O.; Šrůtková, D.; Rada, V.; Rittich, B. Selection of potential probiotic Lactobacillus strains of human origin for use in dairy industry. Eur. Food Res. Technol. 2015, 241, 861–869. [Google Scholar] [CrossRef]
- Graziano, G.; Merlino, A. Molecular bases of protein halotolerance. Biochim. Biophys. Acta Spec. Sect. Prot. Proteom. 2014, 1844, 850–858. [Google Scholar] [CrossRef] [PubMed]
- Laurencio-Silva, M.; Arteaga, F.; Macías, I. Potencial probiótico in vitro de cepas de Lactobacillus spp. procedentes de la vagina de vacas lecheras. Pastos Forrajes 2017, 40, 206–215. [Google Scholar]
- Salas-Tovar, J.A.; Escobedo-García, S.; Olivas, G.I.; Acosta-Muñiz, C.H.; Harte, F.; Sepúlveda, D.R. Method induced variation in the bacterial cell surface hydrophobicity MATH test. J. Microbiol. Methods 2021, 185, 106234. [Google Scholar] [CrossRef]
- García, Y.; Boucourt, R.; Albelo, N.; Núñez, O. Fermentación de inulina por bacterias ácido lácticas con características probióticas. Rev. Cubana Cienc. Agríc. 2007, 41, 263–266. [Google Scholar]
- Bouridane, H.; Sifour, M.; Idoui, T.; Annick, L.; Thonard, P. Technological and probiotic traits of the Lactobacilli isolated from vaginal tract of the healthy women for probiotic use. Iran. J. Biotechnol. 2016, 14, 192–201. [Google Scholar] [CrossRef] [PubMed]
- Rahman, M.M.; Kim, W.S.; Kumura, H.; Shimazaki, K.I. Autoaggregation and surface hydrophobicity of bifidobacteria. World J. Microbiol. Biotechnol. 2008, 24, 1593–1598. [Google Scholar] [CrossRef]
- Cesena, C.; Morelli, L.; Alander, M.; Siljander, T.; Tuomola, E.; Salminen, S. Lactobacillus crispatus and its nonaggregating mutant in human colonization trials. J. Dairy Sci. 2001, 4, 1001–1010. [Google Scholar] [CrossRef]
- García-Cayuela, T.; Korany, A.M.; Bustos, I.; Gómez de Cadiñanos, L.P.; Requena, T.; Peláez, C.; Martínez-Cuesta, M.C. Adhesion abilities of dairy Lactobacillus plantarum strains showing an aggregation phenotype. Food Res. Int. 2014, 57, 44–50. [Google Scholar] [CrossRef]
- Suwannasom, N.; Siriphap, A.; Japa, O.; Thephinlap, C.; Thepmalee, C.; Khoothiam, K. Lactic Acid Bacteria from Northern Thai (Lanna) Fermented Foods: A Promising Source of Probiotics with Applications in Synbiotic Formulation. Foods 2025, 14, 244. [Google Scholar] [CrossRef]
- Nandi, S.; Mandal, S. Probiotic potentiality, safety profiling and broad-spectrum antibacterial activity of lactic acid bacteria isolated from sour curd (Malda, India). Microbe 2025, 7, 100297. [Google Scholar] [CrossRef]
- Huang, H.; Peng, F.; Li, J.; Liu, Z.; Xie, M.; Xiong, T. Isolation and characteristics of lactic acid bacteria with antibacterial activity against Helicobacter pylori. Food Biosci. 2021, 44, 101446. [Google Scholar] [CrossRef]
- He, X.; Cui, Y.; Jia, Q.; Zhuang, Y.; Gu, Y.; Fan, X.; Ding, Y. Response mechanisms of lactic acid bacteria under environmental stress and their application in the food industry. Food Biosci. 2025, 64, 105938. [Google Scholar] [CrossRef]
- Akpoghelie, P.O.; Edo, G.I.; Ali, A.; Yousif, E.; Zainulabdeen, K.; Oghenewogaga, J.; Fegor, E.; Igbuku, U.A.; Athan-Essaghah, A.E.; Makia, R.; et al. Lactic acid bacteria: Nature, characterization, mode of action, products and applications. Process Biochem. 2025, 152, 1–28. [Google Scholar] [CrossRef]
- Xu, Y.; Zhou, T.; Tang, H.; Li, X.; Chen, Y.; Zhang, L.; Zhang, J. Probiotic potential and amylolytic properties of lactic acid bacteria isolated from Chinese fermented cereal foods. Food Control 2020, 111, 107057. [Google Scholar] [CrossRef]
- Shani, N.; Oberhaensli, S.; Arias-Roth, E. Antibiotic susceptibility profiles of Pediococcus pentosaceus from various origins and their implications for the safety assessment of strains with food-technology applications. J. Food Protect. 2021, 84, 1160–1168. [Google Scholar] [CrossRef] [PubMed]
- Baek, J.; Sun Kim, B.; Kim, Y.; Bal, J. Safety, antagonistic activity and probiotic properties of lactic acid bacteria isolated from Jeotgal, Korean fermented seafoods. J. Microbiol. Biotechnol. 2025, 35, e2411055. [Google Scholar] [CrossRef] [PubMed]
- Hopkins, S. The international and national challenges faced in ensuring prudent use of antibiotics. In Antimicrobial Stewardship; Laundry, M., Gilchrist, M., Whitney, L., Eds.; Oxford University Press: Oxford, UK, 2016; pp. 3–11. [Google Scholar]
- Valderrama Membrillo, A. Diversidad de bacterias lácticas del atole agrio de Villahermosa Tabasco. Bachelor’s Thesis, Universidad Nacional Autónoma de México, Ciudad de México, Mexico, 2012. Available online: https://repositorio.unam.mx/contenidos/219739 (accessed on 23 May 2025).
- Hernández Vega, J.V. Producción de atole agrio usando Lactococcus lactis (A1MS3) y Pediococcus pentosaceus (Sol10) como inóculo. Bachelor’s Thesis, Universidad Nacional Autónoma de México, Ciudad de México, Mexico, 2017. Available online: https://ru.dgb.unam.mx/bitstream/20.500.14330/TES01000758654/3/0758654.pdf (accessed on 23 May 2025).
- Porto, M.C.W.; Kuniyoshi, T.M.; Azevedo, P.O.S.; Vitolo, M.; Oliveira, R.P.S. Pediococcus spp.: An important genus of lactic acid bacteria and pediocin producers. Biotechnol. Adv. 2017, 35, 361–374. [Google Scholar] [CrossRef]
- Adesulu-Dahunsi, A.T.; Sanni, A.I.; Jeyaram, K. Diversity and technological characterization of Pediococcus pentosaceus strains isolated from Nigerian traditional fermented foods. LWT Food Sci. Technol. 2021, 140, 110697. [Google Scholar] [CrossRef]
- Dimitrov Todorov, S.; Dioso, C.M.; Liong, M.T.; Nero, L.A.; Khosravi-Darani, K.; Ivanova, I.V. Beneficial features of pediococcus: From starter cultures and inhibitory activities to probiotic benefits. World J. Microbiol. Biotechnol. 2023, 39, 4. [Google Scholar] [CrossRef]
- Väkeväinen, K.; Hernández, J.; Simontaival, A.-I.; Severiano-Pérez, P.; Díaz-Ruiz, G.; von Wright, A.; Wacher-Rodarte, C.; Plumed-Ferrer, C. Effect of different starter cultures on the sensory properties and microbiological quality of Atole agrio, a fermented maize product. Food Control 2020, 109, 106907. [Google Scholar] [CrossRef]
- Zhang, Y.; Kaushik, N.; Park, P.; Liu, R.; Liu, Y. Pediococcus pentosaceus in fermented foods: Probiotic properties and a multi-omics framework for applications. Trends Food Sci. Technol. 2025, 163, 105187. [Google Scholar] [CrossRef]







| Time (h) | pH | Temperature (°C) |
|---|---|---|
| 0 | 6.42 | 22 |
| 1 | 6.05 | 24 |
| 2 | 5.99 | 26 |
| 3 | 5.99 | 30 |
| 4 | 5.99 | 32 |
| 5 | 5.99 | 33 |
| 6 | 5.86 | 34 |
| 7 | 5.28 | 35 |
| 8 | 4.39 | 37 |
| 9 | 4 | 37 |
| 10 | 4 | 37 |
| Microbial Group | Fermentation Start | End of Fermentation | Cooked Product |
|---|---|---|---|
| Aerobic mesophiles | 7.30 ± 3.46 | 7.08 ± 3.34 | n.d. |
| Coliforms | 3.18 ± 0.98 | n.d. | n.d. |
| LAB | 7.30 ± 3.42 | 8.23 ± 3.95 | n.d. |
| Yeasts | 6.00 ± 2.62 | 3.18 ± 1.02 | n.d. |
| Molds | 6.18 ± 2.79 | 2.00 ± 0.32 | n.d. |
| Antibiotic | AG13 | AG29 | AG34 | AG35 | AG40 | AG41 | AG43 |
|---|---|---|---|---|---|---|---|
| Aerobic mesophiles | 3 ± 0.08 | 4 ± 0.18 | 4 ± 0.16 | 4 ± 0.18 | 3 ± 0.07 | 4 ± 0.16 | 3 ± 0.08 |
| Ampicillin 10 μg | 12 ± 0.44 | 10 ± 0.39 | 9 ± 0.32 | 12 ± 0.49 | 11 ± 0.30 | 10 ± 0.37 | 10 ± 0.37 |
| Cephalothin 30 μg | 4 ± 0.11 | 5 ± 0.16 | 5 ± 0.16 | 6 ± 0.32 | 6 ± 0.32 | 6 ± 0.32 | 4 ± 0.11 |
| Cefotaxime 30 μg | 0 | 0 | 0 | 0 | 0 | 0 | 0 |
| Ciprofloxacin 5 μg | 18 ± 0.78 | 20 ± 0.68 | 19 ± 0.64 | 21 ± 0.66 | 19 ± 0.60 | 19 ± 0.61 | 17 ± 0.54 |
| Clindamycin 30 μg | 2 ± 0.07 | 3 ± 0.11 | 1 ± 0.08 | 3 ± 0.10 | 3 ± 0.10 | 2 ± 0.07 | 3 ± 0.11 |
| Dicloxacillin 1 μg | 11 ± 0.35 | 12 ± 0.48 | 11 ± 0.35 | 11 ± 0.36 | 11 ± 0.35 | 11 ± 0.35 | 11 ± 0.34 |
| Erythromycin 15 μg | 2 ± 0.11 | 3 ± 0.18 | 2 ± 0.06 | 1 ± 0.05 | 1 ± 0.06 | 1 ± 0.05 | 2 ± 0.07 |
| Gentamicin 10 μg | 10 ± 0.42 | 12 ± 0.49 | 11 ± 0.32 | 12 ± 0.49 | 11 ± 0.32 | 10 ± 0.41 | 11 ± 0.31 |
| Penicillin 10 U | 5 ± 0.25 | 8 ± 0.28 | 7 ± 0.27 | 5 ± 0.24 | 5 ± 0.25 | 5 ± 0.24 | 6 ± 0.27 |
| Tetracycline 30 μg | 0 | 0 | 0 | 0 | 0 | 0 | 0 |
| Sulfamethoxazole/trimethoprim 23.75/1.25 μg | 0 | 0 | 0 | 0 | 0 | 0 | 0 |
| Vancomycin 30 μg | 3 ± 0.08 | 4 ± 0.18 | 4 ± 0.16 | 3 ± 0.07 | 4 ± 0.16 | 3 ± 0.08 |
Disclaimer/Publisher’s Note: The statements, opinions and data contained in all publications are solely those of the individual author(s) and contributor(s) and not of MDPI and/or the editor(s). MDPI and/or the editor(s) disclaim responsibility for any injury to people or property resulting from any ideas, methods, instructions or products referred to in the content. |
© 2025 by the authors. Licensee MDPI, Basel, Switzerland. This article is an open access article distributed under the terms and conditions of the Creative Commons Attribution (CC BY) license (https://creativecommons.org/licenses/by/4.0/).
Share and Cite
Torres-Gregorio, M.; Ribas-Aparicio, R.M.; Aguilera-Arreola, M.G.; Gutiérrez-López, G.F.; Hernández-Sánchez, H. Probiotic Potential of Some Lactic Acid Bacteria Isolated from Blue Maize Atole Agrio from Veracruz, México. Fermentation 2025, 11, 474. https://doi.org/10.3390/fermentation11080474
Torres-Gregorio M, Ribas-Aparicio RM, Aguilera-Arreola MG, Gutiérrez-López GF, Hernández-Sánchez H. Probiotic Potential of Some Lactic Acid Bacteria Isolated from Blue Maize Atole Agrio from Veracruz, México. Fermentation. 2025; 11(8):474. https://doi.org/10.3390/fermentation11080474
Chicago/Turabian StyleTorres-Gregorio, Margarita, Rosa María Ribas-Aparicio, María Guadalupe Aguilera-Arreola, Gustavo F. Gutiérrez-López, and Humberto Hernández-Sánchez. 2025. "Probiotic Potential of Some Lactic Acid Bacteria Isolated from Blue Maize Atole Agrio from Veracruz, México" Fermentation 11, no. 8: 474. https://doi.org/10.3390/fermentation11080474
APA StyleTorres-Gregorio, M., Ribas-Aparicio, R. M., Aguilera-Arreola, M. G., Gutiérrez-López, G. F., & Hernández-Sánchez, H. (2025). Probiotic Potential of Some Lactic Acid Bacteria Isolated from Blue Maize Atole Agrio from Veracruz, México. Fermentation, 11(8), 474. https://doi.org/10.3390/fermentation11080474

